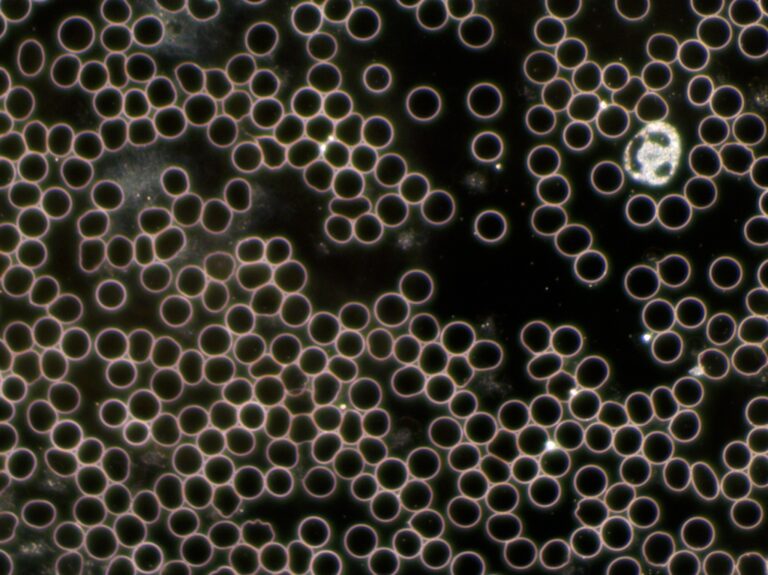
6 (2)

Diagnostik.

Anamnese
Um ein umfangreiches Bild Ihrer Beschwerden und deren ganzheitlichen Zusammenhang zu bekommen, nehme ich mir ausreichend Zeit für die Erstanamnese.
Es geht um Sie als Gesamtpaket-Körper, Psyche, Seele und alles was Sie belastet und einschränkt. Bitte rechnen Sie mit etwa zwei bis drei Stunden Aufwand dafür.
Gib hier deine Überschrift ein
Körperliche
Untersuchung
Ich führe während der Erstanamnese eine komplette körperliche Untersuchung nach der IPPAF Schema durch:
Inspektion,
Palpation,
Perkussion,
Auskultation,
Funktionsprüfung.

HRV Messung-Herzratenvariabilität.
Unser Herzschlag ist variabel, die Zeitintervalle zwischen zwei Herzschlägen sind unterschiedlich. Die Untersuchung der sogenannten Herzratenvariabilität (HRV) gibt einen Einblick über die Funktionsfähigkeit des vegetativen Nervensystems. Sie zeigt uns auf, wie die beiden Anteile, Sympathikus und Parasympathikus arbeiten und wann sie besser aktiviert werden können. Damit ist Stress messbar.
Eine regulative Therapie zielt darauf beide Anteile zu harmonisieren-wir brauchen die sympathische Aktivität um Leistung zu bringen und die parasympathische Aktivität für die Regeneration und Erholung
Die Herzratenvariabilität bei Depression und Burnout ist gut untersucht. Es zeigt sich, dass die eine geringere Variabilität aufweisen, was auf eine reduzierte Aktivierbarkeit des Parasympathikus schließen lässt und somit mehr Stress.
Somit ist es sinnvoll, die Messung der HRV in die Allgemeine Diagnostik und Therapie zu integrieren.
Gib hier deine Überschrift ein

Blut, Serum, Urin, Speichel und Stuhluntersuchungen
In Kollaboration mit Ganzimmun Diagnostics Labor Mainz biete ich Ihnen umfangreiche Diagnostik. Ich berate Sie, auch hier nach dem Prinzip so wenig wie möglich, so viel wie nötig, über die sinnvollsten Untersuchungen..
Gib hier deine Überschrift ein
Dunkelfeldmikroskopie-Vitalblutuntersuchung
Bei dieser Diagnostikmethode wird ein Tropfen Blut aus der Fingerbeere mit einem Dunkelfeldkondensor Mikroskop betrachtet.
Es gibt zwei entscheidende Vorteile dieser Diagnostik:
-keine Notwendigkeit der Zellfärbung, man betrachtet die Blutzellen auf einem schwarzen Hintergrund
-die Möglichkeit der Zelllanglebigkeit und Blutmilieus zu beurteilen.
Dies geschieht vor Ort, zusammen mit Ihnen und anschließend über mehrere Stunden und Tage je nach Zustand des Blutes, deshalb auch Vitalblutuntersuchung- die Betrachtung endet wenn alle Blutzellen sich aufgelöst haben. Die Betrachtungszeiten sind je nach Patient extrem unterschiedlich-von ein paar Stunden- bei z. B. Omega 3 Mangel und sehr instabile Zellmembran, bis zur 16 Tage (bisheriger Patientenrekord).
Ich berechne dafür eine Zeitpauschale von 2 Stunden, unabhängig wie lange die Betrachtung dauert.
Anhand der Zellenform, Beschaffenheit und Anordnung von Zellen und Flüssigkeit lassen sich Veränderungen der Blutregulation erkennen, der mögliche Erkrankungen zugrunde liegen.

Eine sorgfältige und umfassende Diagnostik ist die Basis für die anschließende Behandlung, denn der Blutfluss gibt Auskunft über unseren gesamten Stoffwechsel auch ob das Säure-Basen-Gleichgewicht des Körpers ausgeglichen ist.
Eine Übersäuerung des inneren Milieus entsteht durch multiple Faktoren: psychische, umwelttoxische und in entscheidender Weise durch eine Ernährung die sauer verstoffwechselt wird und überwiegen reich an tierischen Nahrungseiweißen und einfache Kohlenhydrate ist.
Zusätzliche Maßnahmen wie Darmsanierung, Entgiften, Entsäuern, Ernährungsumstellung, Ausleiten, Vorschläge zur Verminderung von Stress, Trainingspläne und ähnlichem sind gegebenenfalls Teil der Therapie.


